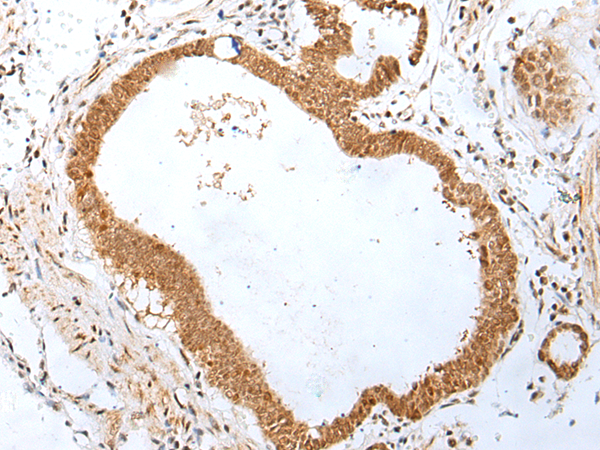
一抗

中文名稱: 兔抗PEG3多克隆抗體
英文名稱: Anti-PEG3 rabbit polyclonal antibody
別 名: PW1; ZNF904; ZSCAN24; ZKSCAN22
抗 原: PEG3
相關類別: 一抗
儲 存: 冷凍(-20℃)
宿 主: Rabbit
反應種屬: Human
標 記 物: Unconjugate
克隆類型: rabbit polyclonal
技術規格
|
Background: |
In human, ZIM2 and PEG3 are treated as two distinct genes though they share multiple 5' exons and a common promoter and both genes are paternally expressed (PMID:15203203). Alternative splicing events connect their shared 5' exons either with the remaining 4 exons unique to ZIM2, or with the remaining 2 exons unique to PEG3. In contrast, in other mammals ZIM2 does not undergo imprinting and, in mouse, cow, and likely other mammals as well, the ZIM2 and PEG3 genes do not share exons. Human PEG3 protein belongs to the Kruppel C2H2-type zinc finger protein family. PEG3 may play a role in cell proliferation and p53-mediated apoptosis. PEG3 has also shown tumor suppressor activity and tumorigenesis in glioma and ovarian cells. Alternative splicing of this PEG3 gene results in multiple transcript variants encoding distinct isoforms. |
|
Applications: |
ELISA, IHC |
|
Name of antibody: |
PEG3 |
|
Immunogen: |
Synthetic peptide of human PEG3 |
|
Full name: |
paternally expressed 3 |
|
Synonyms: |
PW1; ZNF904; ZSCAN24; ZKSCAN22 |
|
SwissProt: |
Q9GZU2 |
|
ELISA Recommended dilution: |
5000-10000 |
|
IHC positive control: |
Human colorectal cancer and Human tonsil |
|
IHC Recommend dilution: |
25-100 |

 購物車
購物車 幫助
幫助
 021-54845833/15800441009
021-54845833/15800441009